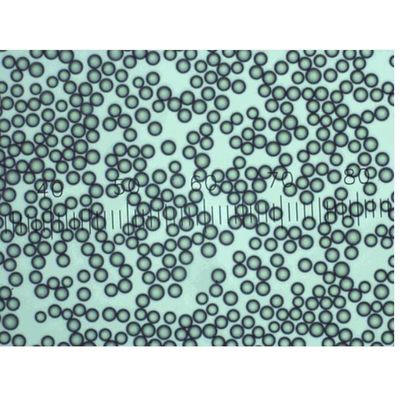

- Home
- Companies
- Applied Physics
- Products
- Applied Physics - Model Dri-Cal - ...
Applied Physics - Model Dri-Cal -Particle Size Standards Beads
FromApplied Physics
Use Applied Physics Dri-Cal Particle Size Standards for calibrating particle sizing and counting instruments that require dry particles.
Most popular related searches
particle sizing
material safety data sheet
safety data sheet
safety data
sampling chamber
respiratory protection
traceable calibration
particle sampling
calibration standard
- Conveniently packaged in dropper-tipped vials in 1 gram quantities, enabling the user to dispense the particles directly into the sampling chamber; not suitable for dispersion in liquid media.
- Contains Certificate of Calibration and Traceability to NIST™, including description of the calibration method and its uncertainty and a table of chemical and physical properties
- Includes Material Safety Data Sheet with handling and disposal instructions
- Lot-numbered for technical service and support
Store at room temperature in a dry area. Store upright and keep bottle tightly sealed. Respiratory protection from dust is recommended.

